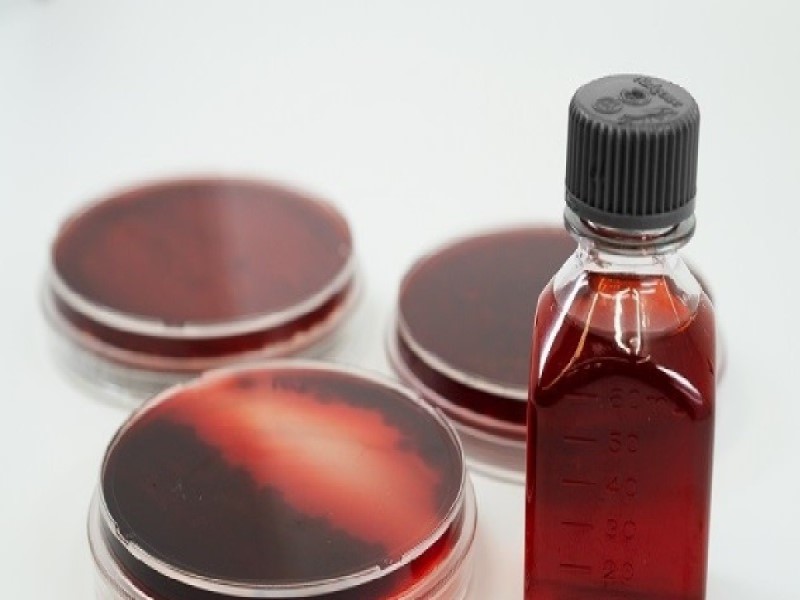
Грибы могут быть использованы для исцеления, но могут также вызывать болезни

Грибы потрясающие создания природы. Вы догадываетесь, насколько они классные?! Мы могли бы продолжать весь день делиться нашими любимыми фактами о грибах, но вот всего десять, начиная от самых забавных, а в некотором роде даже случайных, до тех, которые оказывают прямое влияние на вашу жизнь.
Содержание
- Грибы больше похожи на животных, чем на растения
- У грибов более двух полов
- Не все грибки производят грибы
- Грибы могут переваривать целлюлозу — то, чего не могут сделать ни растения, ни животные
- Некоторые грибы взаимодействуют с растениями
- Лишайник — часть грибка
- Грибы могут быть использованы для исцеления, но могут также вызывать болезни
- Из некоторых грибов можно сделать краситель
- Самый большой организм в мире — это гриб
- Грибы, вероятно, спасли вам жизнь
1. Грибы больше похожи на животных, чем на растения.
В течение многих лет ученые относили грибы к растениям — некоторые до сих пор называют их так. Это правда, что грибы, как и растения, не имеют мышечной ткани и поэтому могут двигаться только путем роста. Но как только ученые научились приглядываться, они поняли, что почти все остальное в грибах больше похоже на животных.
Грибы, как и животные, должны есть, чтобы получать энергию. Некоторые даже являются активными охотниками, ловя червей нематод в маленьких подземных петлях. Грибы, как и животные, должны иметь источник свежего воздуха для дыхания. Им нужен кислород. Растения тоже нуждаются в кислороде, разница в том, что, поскольку растения производят весь кислород, который им нужен, и даже больше, им не нужно его вдыхать. Грибы, как и животные, нуждаются именно в «дыхании». Грибы, как и животные, нуждаются в витамине D и могут синтезировать его, подвергая определенные вещества воздействию солнечного света. И хотя клетки грибов имеют стенки (в отличие от клеток животных), эти стенки состоят из хитина, того же вещества, из которого состоят экзоскелеты насекомых.
Ясно, что грибы — это не животные. Они принадлежат своему отдельному королевству. Но грибное царство — наш близкий сосед.
2. У грибов более двух полов.
Большинство людей, вероятно, полагают, что грибы используют споры для размножения, если вообще задумываются об этом. Это правда, что грибы производят их, что является своего рода грибным эквивалентом семенам, но образование спор — лишь часть процесса. Другая важная часть — это спаривание. Грибы вступают в половую связь, когда растущие кончики грибковых нитей (гиф) встречаются и сливаются. Плод вырастает из этой точки слияния. Генетический маркер идентифицирует каждый гриб как принадлежащий к «типу спаривания» и предотвращает спаривание гиф одного и того же типа.
Типы спаривания — это пол, в том смысле, что гриб должен найти партнера правильного типа, чтобы произвести потомство. Но поскольку типы точно такие же, за исключением их идентификационных маркеров (без яиц, без самцов или самок), вид грибов может просто начать добавлять дополнительные полы, без проблем. Чем больше полов у вида, тем больше вероятность того, что особи найдут себе пару, отличную от них самих. Есть по крайней мере один вид с тысячами полов.
3. Не все грибки производят грибы.
Многие люди думают о грибах как о растениях, воображая, что мицелий аналогичен корням. Фактически, мицелий — это основная часть тела гриба, та часть, которая ест, дышит, спаривается и так далее. Гриб — это просто плодовое тело, на котором образуются и высвобождаются споры. Да и вообще не все грибки выращивают грибы.
Некоторые грибки выпускают свои споры из пуха, корки или других структур, не имеющих грибовидного происхождения. Некоторые грибки, такие как дрожжи, одноклеточные и, следовательно, вообще не имеют структур, продуцирующих споры.
4. Грибы могут переваривать целлюлозу — то, чего не могут сделать ни растения, ни животные.
Вы когда-нибудь задумывались, почему деревья не худеют? Конечно, они могут сбрасывать листья и даже ветви, но толстое дерево не «похудеет», если слишком много дней проходит без солнечного света. Это очень отличается от того, как ведет себя организм животных при недостатке питания. За очень немногими исключениями (волосы, молочные зубы) мы не теряем ненужные части, а реабсорбируем их. Наш жир, наши мышцы, даже наши кости могут стать тоньше и легче, если нам понадобится повторно использовать эти питательные вещества в другом месте. Так почему же деревья не могут делать то же самое?
Причина в том, что наши тела могут усваивать мясо, в том числе то, из которого состоит наше тело — мы можем перерабатывать сами себя — но растения не могут усваивать целлюлозу. Животные тоже не могут. Термиты и другие едоки древесины имеют в кишечнике микроорганизмы, которые переваривают древесину за них. Некоторые грибы, особенно те, которые вызывают «коричневую гниль», действительно обладают необычной способностью поедать целлюлозу. Если бы не они, мертвые деревья по большей части просто оставались бы, никуда не исчезая, накапливая огромные груды на земле.
5. Некоторые грибы взаимодействуют с растениями.
Многие растения, в том числе большинство деревьев и все орхидеи, не имеют очень эффективных корневых систем — вместо этого их корни взаимодействуют с грибами, которых они кормят сахаром в обмен на воду и минералы. Один гриб может взаимодействовать с несколькими деревьями (даже деревьями разных видов) и, следовательно, может брать сахар с одного дерева и передавать его другому, возможно, тому, которому не хватает солнечного света. Поддержание здоровья всех деревьев в сети в конечном итоге лучше для грибов. Деревья также могут напрямую соединять свои корни, но грибы являются важной частью того, что было названо «всемирной паутиной», посредством которой деревья общаются и взаимодействуют.
Не все грибы могут образовывать эти микоризные партнерства, но некоторые из наших самых известных видов могут. Например, большинство сморчков микоризных.
6. Лишайник — часть грибка
Лишайники, которые могут напоминать корки или мхи, или даже листья или крошечные деревья, представляют собой партнерство между грибами и водорослями или цианобактериями. Грибок обеспечивает защитную структуру, в то время как водоросли или цианобактерии внутри него обеспечивают сахар, производимый фотосинтезом. Лишайники важны для развития почвы на ранее обнаженных камнях или песках и составляют значительную часть биомассы некоторых лесов. Некоторые из них съедобны или полезны в медицине. Они являются основным источником пищи северных оленей. Об удивительных и завораживающих странностях лишайников можно продолжать говорить очень много. Хотя каждый вид лишайников на самом деле представляет собой комбинацию двух или трех видов, ученые рассматривают типы лишайников как группы — так проще.
Одна из самых странных особенностей лишайников — это то, что грибы, образующие их, не связаны друг с другом тесно. Многие лишайниковые грибы более связаны с нелихенизированными видами, чем с другими лишайниками.
7. Грибы могут быть использованы для исцеления, но могут также вызывать болезни.
Обычно, когда мы говорим о грибах и здоровье, мы говорим о лекарственных грибах или о ядовитых. В любом случае, нас интересует, как грибы воздействуют на наш организм. Некоторые грибы могут привести к плачевным последствиям.
Большинство грибковых заболеваний поражает растения. На самом деле, большинство болезней, которыми болеют растения, вызываются грибами. Но есть несколько грибов, которые могут поражать животных, в том числе человека. Некоторые виды Candida естественным образом живут на людях и являются частью нашего здорового микробиома, но, если что-то вызывает неконтролируемый рост дрожжей или если дрожжи попадают в кровоток, где они обычно не растут, они могут вызвать болезнь. Спортивная стопа и стригущий лишай также являются распространенными грибковыми инфекциями. Есть и более редкие и более серьезные примеры, в том числе некоторые виды-производители грибов, которые могут атаковать людей с ослабленным иммунитетом. Грибковые инфекции обычно легко поддаются лечению после правильной диагностики. Как ни странно, хотя Кандида — это грибок, его также можно лечить другими грибами.
8. Из некоторых грибов можно сделать краситель.
Многие грибы, некоторые съедобные, а некоторые нет, можно использовать для изготовления красителей. Цвет зависит как от вида, так и от того, как он обрабатывается, то есть из одного вида можно получить более одного цвета. Возможные цвета включают коричневый, красный, синий и зеленый, обычно тусклый, но приятный «землистый» оттенок. Есть организованные группы энтузиастов грибной окраски, так же как есть поклонники любого другого вида использования грибов.
9. Самый большой организм в мире — это гриб.
Какое самое большое живое существо? Это синий кит? Красное дерево? Нет, это грибок, в частности опята в Монтане. Они нападают на живые деревья, в конечном итоге убивая их, и могут распространяться с одного дерева на другое под землей. Эта особь распространилась от дерева к дереву на многие мили. Человек, гуляющий по лесу, может не заметить ничего необычного — во всех здоровых лесах есть грибы, а во всех здоровых лесах, кроме очень молодых, есть несколько больных и умирающих деревьев. Опята не являются чем-то необычным. Странно только то, что в этом лесу, на многие мили вокруг, все опята, пробирающиеся сквозь мертвую и умирающую древесину, — одного вида.
10. Грибы, вероятно, спасли вам жизнь.
Грибы известны тем, что их используют в альтернативной медицине, хотя очень немногие из этих применений были подтверждены медицинской наукой. Но есть однозначное лекарственное применение грибка: пенициллин и многие другие антибиотики производятся с помощью плесени. Плесень — это грибки. Без антибиотиков простой инфицированный порез от бумаги может быть смертельным, не говоря уже о таких заболеваниях, как скарлатина, туберкулез или даже проказа, заболеваниях, которые когда-то терроризировали население, а теперь стали редкими и, по большей части, поддающимися лечению. И это не говоря уже о хлебе, пиве, чайном грибе и некоторых молочных продуктах, которых бы не существовало, если бы не дрожжи, еще одна ветвь грибного царства. Без грибов многие из нас были бы больны и голодны — или их просто больше не было бы здесь. Грибы много за что можно поблагодарить.